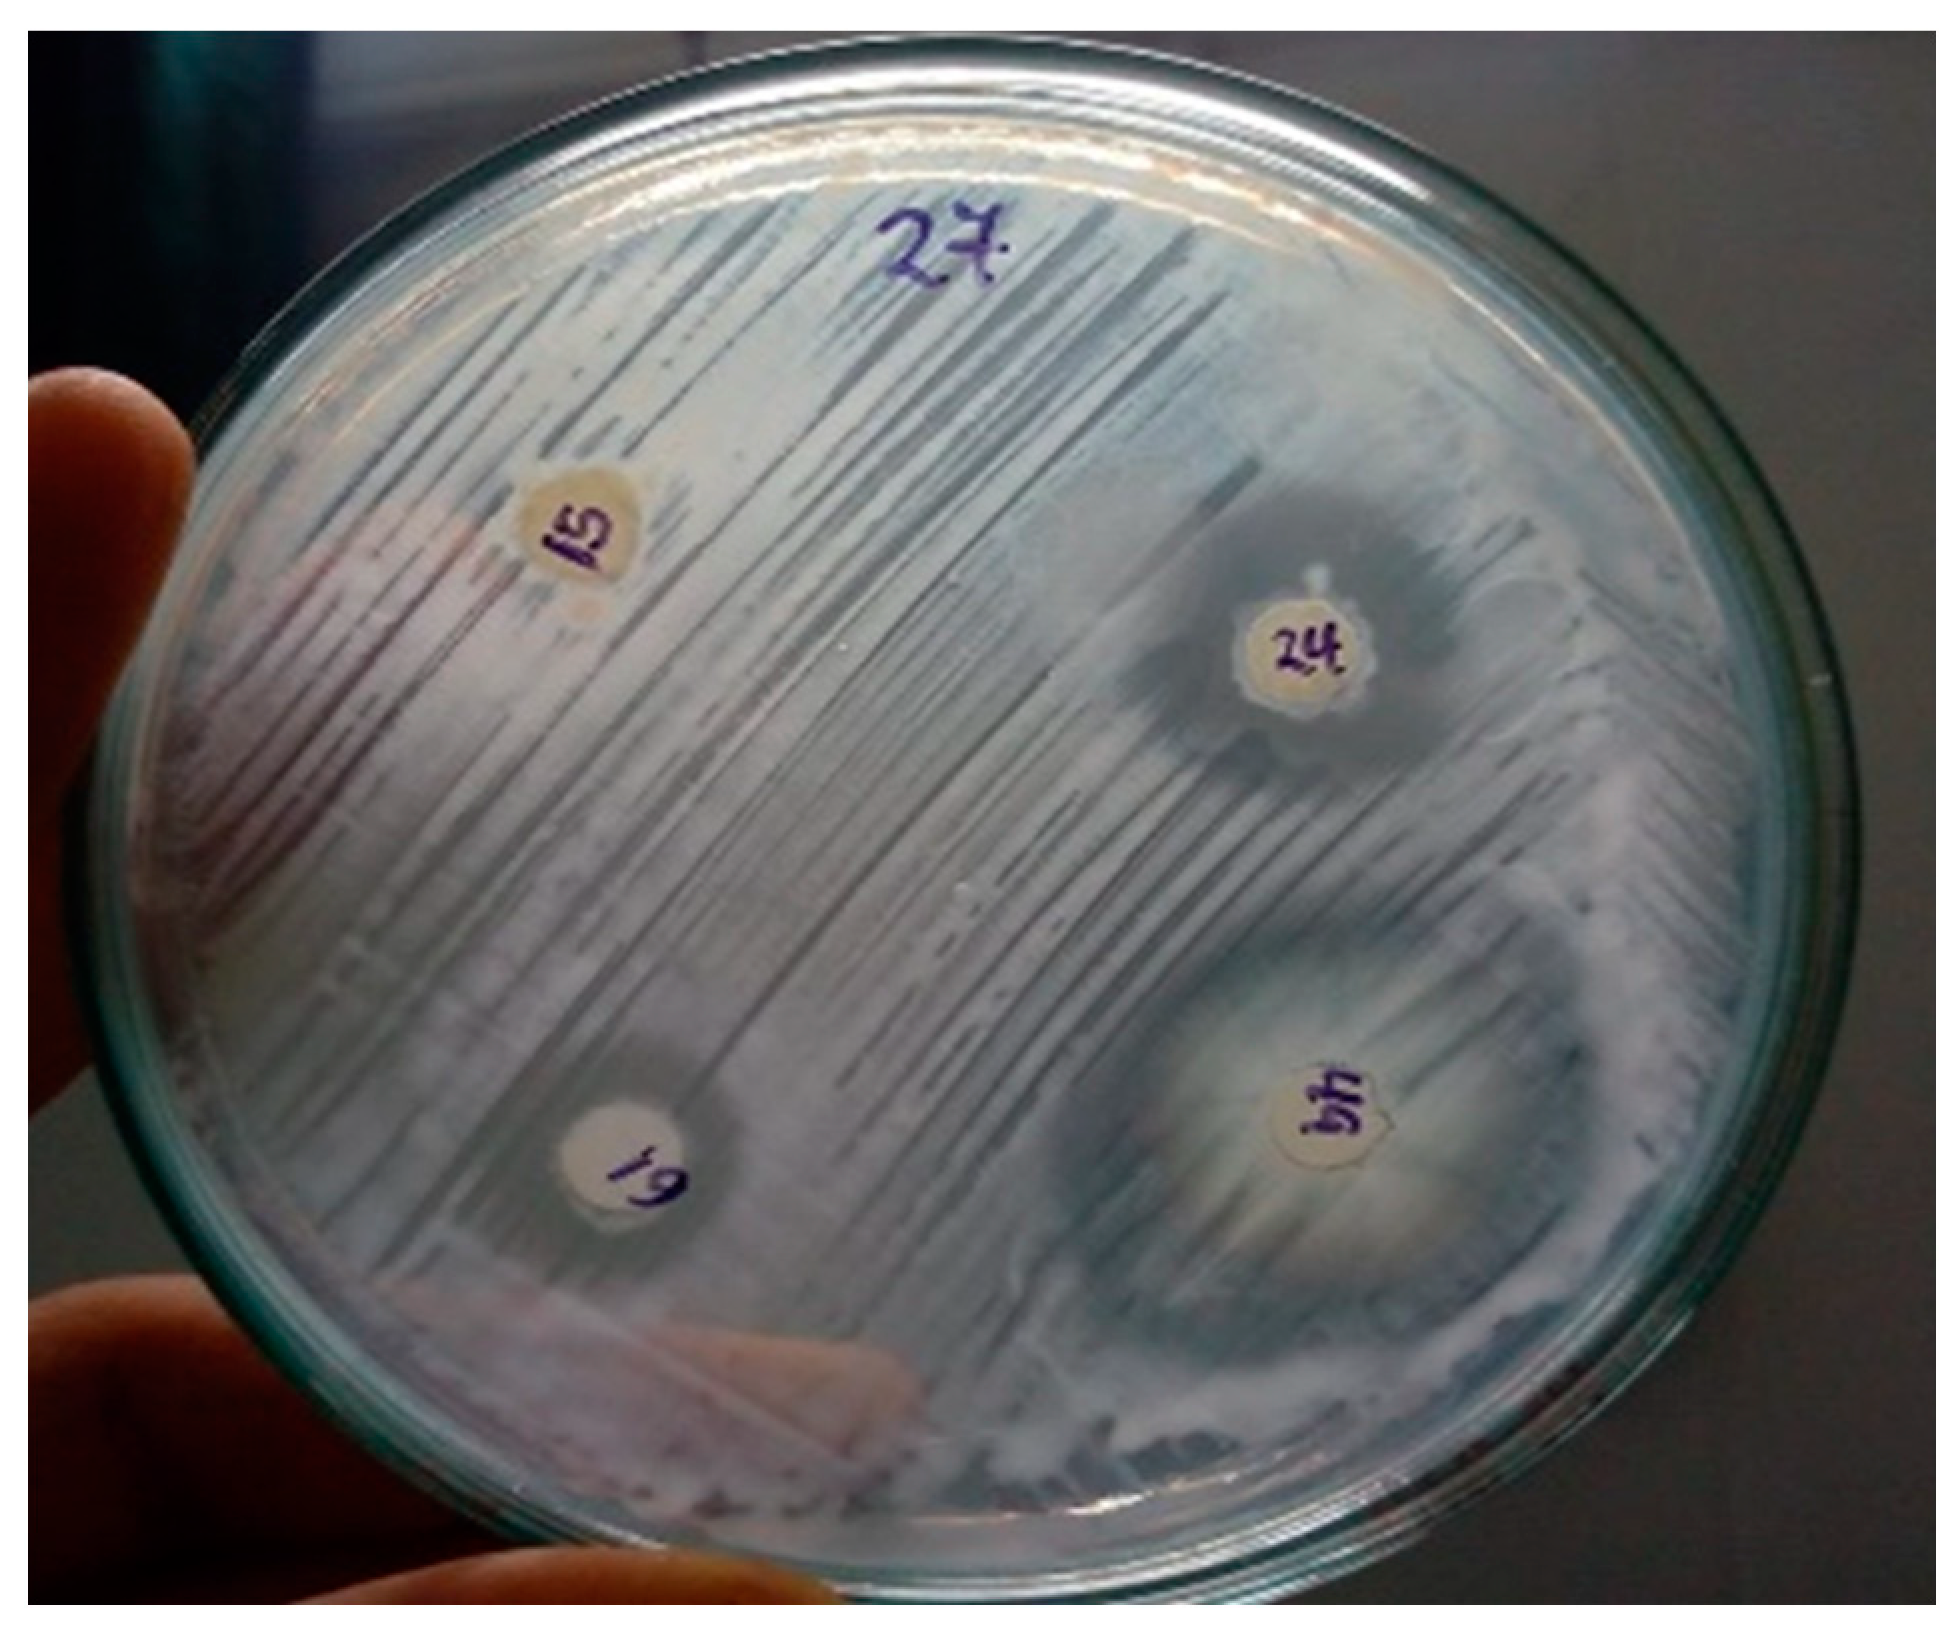
Agronomy 14 02493 g001

Co-Inoculation of Phosphate-Solubilizing Bacteria and Rhizobia Increases Phosphorus Availability and Promotes the Development of Forage Legumes
Abstract
1. Introduction
2. Materials and Methods
2.1. Biological Material
2.2. Antagonism Test
2.3. Quantification of Bacterial Growth
2.4. Experimental Setup and Implementation
2.5. Statistical Design
3. Results
3.1. Soil Analysis
3.2. Inhibition Test
3.3. Bacterial Growth Analysis
3.4. Evaluation of Co-Inoculation Between PSB, Rhizobia, and Legumes in Semi-Controlled Conditions in a Shade House
3.4.1. Plant Development in Semi-Controlled Conditions in a Shade House
3.4.2. Chlorophyll Level in the Plant (SPAD)
3.4.3. Plant Height (cm)
3.4.4. Dry Biomass of Aerial Part (mg)
3.4.5. Dry Root Biomass (mg)
3.4.6. Root Length (cm)
3.4.7. Leaf Phosphorus (P) (ppm)
3.4.8. Phosphorus (P) in Soil (ppm)
4. Discussion
5. Conclusions
Author Contributions
Funding
Data Availability Statement
Acknowledgments
Conflicts of Interest
References
- Ebrahimi, E.; Ojani, M.R. Phosphorus Dynamics in Soil-Water-Sediment Environment. In Phosphorus in Soils and Plants; IntechOpen: London, UK, 2024. [Google Scholar] [CrossRef]
- Ríos-Ruiz, W.F.; Casique-Huamanguli, R.D.; Valdez-Nuñez, R.A.; Rojas-García, J.C.; Calixto-García, A.R.; Ríos-Reátegui, F.; Pompa-Vásquez, D.F.; Padilla-Santa-Cruz, E. Rhizospheric Bacteria of Cover Legumes from Acidic Soils Are Capable of Solubilizing Different Inorganic Phosphates. Microorganisms 2024, 12, 1101. [Google Scholar] [CrossRef] [PubMed]
- Liang, C.; Liu, X.; Feng, L.; Jin, N.; Lv, J.; Yu, Q. Optimizing Phosphorus Fertilizer Use on the Loess Plateau: Impact on Soil Properties and Crop Production Efficiency. Soil Syst. 2024, 8, 3. [Google Scholar] [CrossRef]
- Haynes, R.J.; Naidu, R. Phosphorus—An essential input for agriculture yet a key pollutant of surface waters. In Inorganic Contaminants and Radionuclides; Elsevier: Amsterdam, The Netherlands, 2024; pp. 405–426. [Google Scholar] [CrossRef]
- Srivastav, A.L.; Patel, N.; Rani, L.; Kumar, P.; Dutt, I.; Maddodi, B.S.; Chaudhary, V.K. Sustainable options for fertilizer management in agriculture to prevent water contamination: A review. Environ. Dev. Sustain. 2024, 26, 8303–8327. [Google Scholar] [CrossRef]
- Cordell, D.; Drangert, J.O.; White, S. The story of phosphorus: Global food security and food for thought. Glob. Environ. Chang. 2009, 19, 292–305. [Google Scholar] [CrossRef]
- Mcdowell, R.; Pletnyakov, P.; Haygarth, P. Phosphorus applications adjusted to optimal crop yields can help sustain global phosphorus reserves. Nat. Food 2024, 5, 332–339. [Google Scholar] [CrossRef]
- Reed, L.; Glick, B.R. The recent use of plant-growth-promoting bacteria to promote the growth of agricultural food crops. Agriculture 2023, 13, 1089. [Google Scholar] [CrossRef]
- Iftikhar, A.; Farooq, R.; Akhtar, M.; Khalid, H.; Hussain, N.; Ali, Q.; Malook, S.; Ali, D. Implicaciones ecológicas y sostenibles de los microorganismos solubilizadores de fósforo en el suelo. Discov. Appl. Sci. 2024, 6, 33. [Google Scholar] [CrossRef]
- Khan, N.; Siddiqui, M.H.; Ahmad, S.; Ahmad, M.M.; Siddiqui, S. New Insights in Enhancing the Phosphorus Use Efficiency using Phosphate-Solubilizing Microorganisms and Their Role in Cropping System. Geomicrobiol. J. 2024, 4, 485–495. [Google Scholar] [CrossRef]
- Ríos-Ruiz, W.F.; Tarrillo-Chujutalli, R.E.; Rojas-García, J.C.; Tuanama-Reátegui, C.; Pompa-Vásquez, D.F.; Zumaeta-Arévalo, C.A. The Biotechnological Potential of Plant Growth-Promoting Rhizobacteria Isolated from Maize (Zea mays L.) Cultivations in the San Martin Region, Peru. Plants 2024, 13, 2075. [Google Scholar] [CrossRef]
- Dastager, S.G.; Deepa, C.K.; Pandey, A. Isolation and characterization of novel plant growth promoting Micrococcus sp. NII-0909 and its interaction with cowpea. Plant Physiol. Biochem. 2010, 48, 987–992. [Google Scholar] [CrossRef]
- Sawada, H.; Ieki, H.; Oyaizu, H.; Matsumoto, S. Proposal for rejection of Agrobacterium tumefaciens and revised descriptions for the genus Agrobacterium and for Agrobacterium radiobacter and Agrobacterium rhizogenes. Int. J. Syst. Evol. Microbiol. 1993, 43, 694–702. [Google Scholar] [CrossRef] [PubMed]
- Majhi, K.; Let, M.; Bandopadhyay, R. Efficacious use of Micrococcus yunnanensis GKSM13 for the growth of rice seedlings under copper stress with elucidation into genomic traits. Curr. Plant Biol. 2024, 37, 100318. [Google Scholar] [CrossRef]
- Ejaz, S.; Batool, S.; Anjum, M.A.; Naz, S.; Qayyum, M.F.; Naqqash, T.; Shah, K.H.; Ali, S. Effects of inoculation of root-associative Azospirillum and Agrobacterium strains on growth, yield and quality of pea (Pisum sativum L.) grown under different nitrogen and phosphorus regimes. Sci. Hortic. 2020, 270, 109401. [Google Scholar] [CrossRef]
- Shome, S.; Barman, A.; Solaiman, Z.M. Rhizobium and phosphate solubilizing bacteria influence the soil nutrient availability, growth, yield, and quality of soybean. Agriculture 2022, 12, 1136. [Google Scholar] [CrossRef]
- Wendimu, A.; Yoseph, T.; Ayalew, T. Ditching phosphatic fertilizers for phosphate-solubilizing biofertilizers: A step towards sustainable agriculture and environmental health. Sustainability 2023, 15, 1713. [Google Scholar] [CrossRef]
- Alzate Zuluaga, M.Y.; Fattorini, R.; Cesco, S.; Pii, Y. Plant-microbe interactions in the rhizosphere for smarter and more sustainable crop fertilization: The case of PGPR-based biofertilizers. Front. Microbiol. 2024, 15, 1440978. [Google Scholar] [CrossRef]
- Seghouani, M.; Bravin, M.N.; Mollier, A. Crop response to nitrogen-phosphorus colimitation: Theory, experimental evidences, mechanisms, and models. A review. Agron. Sustain. Dev. 2024, 44, 3. [Google Scholar] [CrossRef]
- Abd-Alla, M.H.; Al-Amri, S.M.; El-Enany, A.W.E. Enhancing Rhizobium–Legume Symbiosis and Reducing Nitrogen Fertilizer Use Are Potential Options for Mitigating Climate Change. Agriculture 2023, 13, 2092. [Google Scholar] [CrossRef]
- Lizcano-Toledo, R.; Reyes-Martín, M.P.; Celi, L.; Fernández-Ondoño, E. Phosphorus dynamics in the soil–plant–environment relationship in cropping systems: A review. Appl. Sci. 2021, 11, 11133. [Google Scholar] [CrossRef]
- Notenbaert, A.M.; Douxchamps, S.; Villegas, D.M.; Arango, J.; Paul, B.K.; Burkart, S.; Rao, I.; Kettle, C.J.; Rudel, T.; Vazquez, E.; et al. Tapping into the environmental co-benefits of improved tropical forages for an agroecological transformation of livestock production systems. Front. Sustain. Food Syst. 2021, 5, 742842. [Google Scholar] [CrossRef]
- Shah, G.A.; Sadiq, M.; Iqbal, Z.; Shakoor, N.; Shahid, M.; Aulakh, A.M.; Arthur, K.; Khan, N.; Ismail, I.M.I.; Rashid, M.I. Field co-inoculation of Bradyrhizobium sp. and Pseudomonas increases nutrients uptake of Vigna radiata L. from fertilized soil. J. Plant Nutr. 2023, 46, 1296–1313. [Google Scholar] [CrossRef]
- Ramírez-Bahena, M.H.; Chahboune, R.; Velázquez, E.; Gómez-Moriano, A.; Mora, E.; Peix, A.; Toro, M. Centrosema is a promiscuous legume nodulated by several new putative species and symbiovars of Bradyrhizobium in various American countries. Syst. Appl. Microbiol. 2013, 36, 392–400. [Google Scholar] [CrossRef] [PubMed]
- Frahat, M.G.; El-Settawy, A.A.; Shehata, R.A. Influence of Rhizobia Inoculation and Rock-Phosphate on Biomass and Nitrogen Content of Leucaena leucocephala (Lam.) De Wit Seedlings. Alex. Sci. Exch. J. 2018, 39, 762–770. [Google Scholar] [CrossRef]
- Bageel, A.; Honda, M.D.; Carrillo, J.T.; Borthakur, D. Giant leucaena (Leucaena leucocephala subsp. glabrata): A versatile tree-legume for sustainable agroforestry. Agrofor. Syst. 2020, 94, 251–268. [Google Scholar] [CrossRef]
- De Angelis, A.; Gasco, L.; Parisi, G.; Danieli, P.P. A Multipurpose Leguminous Plant for the Mediterranean Countries: Leucaena leucocephala as an Alternative Protein Source: A Review. Animals 2021, 11, 2230. [Google Scholar] [CrossRef]
- Liu, Z.; Li, Y.C.; Zhang, S.; Fu, Y.; Fan, X.; Patel, J.S.; Zhang, M. Characterization of phosphate-solubilizing bacteria isolated from calcareous soils. Appl. Soil Ecol. 2015, 96, 217–224. [Google Scholar] [CrossRef]
- Ferreira, E.; Nogueira, M.A.; Hungria, M.A. Manual de Análises de Bioinsumos Para uso Agrícola: Inoculantes. Brasília-DF. Embrapa 2024, 164. Available online: https://www.alice.cnptia.embrapa.br/alice/bitstream/doc/1163171/1/Livro-Analises-Bioinsumos-completo-final.pdf (accessed on 8 August 2024).
- Valdez-Nuñez, R.A.; Rojas-García, J.C.; Ríos-Ruiz, W.F. Microbiological indicators of tropical soils quality in ecosystems of the north-east area of Peru. Sci. Agropecu. 2019, 10, 217–227. [Google Scholar] [CrossRef]
- Ríos-Ruiz, W.F.; Barrios-López, L.; Rojas-García, J.C.; Valdez-Nuñez, R.A. Mycotrophic capacity and diversity of native arbuscular mycorrhizal fungi isolated from degraded soils. Sci. Agropecu. 2019, 10, 99–108. [Google Scholar] [CrossRef]
- Tokgöz, S.; Lakshman, D.K.; Ghozlan, M.H.; Pinar, H.; Roberts, D.P.; Mitra, A. Soybean nodule-associated non-rhizobial bacteria inhibit plant pathogens and induce growth promotion in tomato. Plants 2020, 9, 1494. [Google Scholar] [CrossRef]
- Ríos-Ruiz, W.F.; Torres-Chávez, E.E.; Torres-Delgado, J.; Rojas-García, J.C.; Bedmar, E.J.; Valdez-Nuñez, R.A. Inoculation of bacterial consortium increases rice yield (Oryza sativa L.) reducing applications of nitrogen fertilizer in San Martin region, Peru. Rhizosphere 2020, 14, 100200. [Google Scholar] [CrossRef]
- Ríos-Ruiz, W.F.; Tuanama-Reátegui, C.; Huamán-Córdova, G.; Valdez-Nuñez, R.A. Co-Inoculation of Endophytes Bacillus siamensis TUR07-02b and Priestia megaterium SMBH14-02 Promotes Growth in Rice with Low Doses of Nitrogen Fertilizer. Plants 2023, 12, 524. [Google Scholar] [CrossRef] [PubMed]
- Wei, X.; Xie, B.; Wan, C.; Song, R.; Zhong, W.; Xin, S.; Song, K. Enhancing soil health and plant growth through microbial fertilizers: Mechanisms, benefits, and sustainable agricultural practices. Agronomy 2024, 14, 609. [Google Scholar] [CrossRef]
- Gupta, S.; Sundar, S.K. Kinetics of Microbial Growth, Substrate Consumption, and Product Formation. In Recent Advances in Bioprocess Engineering and Bioreactor Design; Dhagat, S., Jujjavarapu, S.E., Sampath Kumar, N., Mahapatra, C., Eds.; Springer: Singapore, 2024; pp. 75–114. [Google Scholar] [CrossRef]
- Menka, K.; Preeti, S.; Kavindra, K.K.; Anil, K. Microbial Inoculants as Plant Biostimulants: A Review on Risk Status. Life 2022, 13, 12. [Google Scholar] [CrossRef]
- Elkoca, E.; Turan, M.; Donmez, M.F. Effects of single, dual and triple inoculations with Bacillus subtilis, Bacillus megaterium and Rhizobium leguminosarum bv. Phaseoli on nodulation, nutrient uptake, yield and yield parameters of common bean (Phaseolus vulgaris l. cv.‘elkoca-05’). J. Plant Nutr. 2010, 33, 2104–2119. [Google Scholar] [CrossRef]
- Argaw, A. Evaluation of co-inoculation of Bradyrhizobium japonicum and Phosphate solubilizing Pseudomonas spp. effect on soybean (Glycine max L. Merr.) in Assossa Area. J. Agric. Sci. Technol. 2012, 14, 213–224. [Google Scholar]
- Singh, O.; Gupta, M.; Mittal, V.; Kiran, S.; Nayyar, H.; Gulati, A.; Tewari, R. Novel phosphate solubilizing bacteria Pantoea cypripedii PS1’along with Enterobacter aerogenes PS16 and Rhizobium ciceri enhance the growth of chickpea (Cicer arietinum L.). Plant Growth Regul. 2014, 73, 79–89. [Google Scholar] [CrossRef]
- Cubillos-Hinojosa, J.G.; de Sá, E.L.S.; Muniz, A.W.; Dick, D.P. Combined application of humic substances and PGPR inoculated and co-inoculated in plants of Phaseolus lunatus (L.) and Leucaena leucocephala (Lam.) de Wit. Rev. Colomb. Cienc. Hort. 2024, 18, e17621. [Google Scholar] [CrossRef]
- Li, H.P.; Han, Q.Q.; Liu, Q.M.; Gan, Y.N.; Rensing, C.; Rivera, W.L.; Zhao, Q.; Zhang, J.L. Roles of phosphate-solubilizing bacteria in mediating soil legacy phosphorus availability. Microbiol. Res. 2023, 272, 127375. [Google Scholar] [CrossRef]
- Liu, L.; Gao, Y.; Yang, W.; Liu, J.; Wang, Z. Community metagenomics reveals the processes of nutrient cycling regulated by microbial functions in soils with P fertilizer input. Plant Soil 2024, 499, 139–154. [Google Scholar] [CrossRef]
- da Silva, F.B.; Barbosa, J.Z.; Tiecher, T.; Borin, J.B.M.; Treichel, B.; de Sá, E.L.S. Species-dependent effect of rhizobacteria co-inoculation in legume plants: A global meta-analysis. Rhizosphere 2024, 30, 100869. [Google Scholar] [CrossRef]
- Zhang, W.; Mao, G.; Zhuang, J.; Yang, H. The co-inoculation of Pseudomonas chlororaphis H1 and Bacillus altitudinis Y1 promoted soybean [Glycine max (L.) Merrill] growth and increased the relative abundance of beneficial microorganisms in rhizosphere and root. Front. Microbiol. 2023, 13, 1079348. [Google Scholar] [CrossRef]
- Qureshi, M.A.; Iqbal, A.; Akhtar, N.; Shakir, M.A.; Khan, A. Co-inoculation of phosphate solubilizing bacteria and rhizobia in the presence of L-tryptophan for the promotion of mash bean (Vigna mungo L.). Soil Environ. 2012, 31, 47–54. [Google Scholar]
- Pang, F.; Li, Q.; Solanki, M.K.; Wang, Z.; Xing, Y.X.; Dong, D.F. Soil phosphorus transformation and plant uptake driven by phosphate-solubilizing microorganisms. Front. Microbiol. 2024, 15, 1383813. [Google Scholar] [CrossRef] [PubMed]
- Chen, Z.; Wang, L.; Cardoso, J.A.; Zhu, S.; Liu, G.; Rao, I.M.; Lin, Y. Improving phosphorus acquisition efficiency through modification of root growth responses to phosphate starvation in legumes. Front. Plant Sci. 2023, 14, 1094157. [Google Scholar] [CrossRef]
- Dai, H.; Wei, S.; Li, J.; Kong, W.; Wang, B.; Pei, J.; Wu, J. Fertilization effects on symbiotic and free-living biological nitrogen fixations: Similar effects but different mechanisms. Appl. Soil Ecol. 2024, 202, 105590. [Google Scholar] [CrossRef]
- Benjelloun, I.; Thami Alami, I.; El Khadir, M.; Douira, A.; Udupa, S.M. Co-inoculation of Mesorhizobium ciceri with either Bacillus sp. or Enterobacter aerogenes on chickpea improves growth and productivity in phosphate-deficient soils in dry areas of a Mediterranean region. Plants 2021, 10, 571. [Google Scholar] [CrossRef]
- Janati, W.; Benmrid, B.; Elhaissoufi, W.; Zeroual, Y.; Nasielski, J.; Bargaz, A. Will Phosphate Bio-Solubilization Stimulate Biological Nitrogen Fixation in Grain Legumes? Front. Agron. 2021, 3, 637196. [Google Scholar] [CrossRef]
- Yu, Y.; Zhang, Q.; Kang, J.; Xu, N.; Zhang, Z.; Deng, Y.; Gillings, M.; Lu, T.; Qian, H. Effects of organic fertilizers on plant growth and the rhizosphere microbiome. Appl. Environ. Microbiol. 2024, 90, e01719-23. [Google Scholar] [CrossRef]
- Gupta, S.; Pandey, S. Exploiting the potential of plant growth-promoting rhizobacteria in legume production. In Abiotic Stress Legumes; Academic Press: Cambridge, MA, USA, 2021; pp. 1–32. [Google Scholar] [CrossRef]
- Hasan, A.; Tabassum, B.; Hashim, M.; Khan, N. Role of plant growth promoting rhizobacteria (PGPR) as a plant growth enhancer for sustainable agriculture: A review. Bacteria 2024, 3, 59–75. [Google Scholar] [CrossRef]
- Singh, S.; Ashoka, P.; Ahlawat, U.; Changdeo, W.B.; Rehsawla, R.; Naruka, A.; Sharma, D. Mechanisms and Applications of Microbial Biotechnology in Soil Health and Agricultural Productivity: A Review. J. Adv. Biol. Biotechnol. 2024, 27, 1420–1438. [Google Scholar] [CrossRef]
- Shi, X.; Qiu, S.; Ji, L.; Lu, H.; Wu, S.; Chen, Q.; Zou, X.; Hu, Q.; Feng, T.; Chen, S.; et al. Pathogenetic characterization of a Micrococcus luteus strain isolated from an infant. Front. Pediatr. 2023, 11, 1303040. [Google Scholar] [CrossRef] [PubMed]
- Azizi-Dargahlou, S.; Pouresmaeil, M. Agrobacterium tumefaciens-Mediated Plant Transformation: A Review. Mol. Biotechnol. 2024, 66, 1563–1580. [Google Scholar] [CrossRef]
- Bautista, C.; Arredondo-Nuñez, A.; Intiquilla, A.; Flores-Fernández, C.N.; Brandelli, A.; Jiménez-Aliaga, K.; Zavaleta, A.I. One-step purification and characterization of a haloprotease from Micrococcus sp. PC7 for the production of protein hydrolysates from Andean legumes. Arch. Microbiol. 2024, 206, 377. [Google Scholar] [CrossRef] [PubMed]
- Devi, R.; Alsaffar, M.F.; AL-Taey, D.K.; Kumar, S.; Negi, R.; Sharma, B.; Singh, S.; Rai, A.K.; Rustagi, S.; Yafav, A.; et al. Effect of indigenous mineral availing microbial consortia and cattle manure combination for growth of maize (Zea mays L.). In Vegetos; Springer: Berlin/Heidelberg, Germany, 2024; pp. 1–12. [Google Scholar] [CrossRef]
- Kaur, T.; Devi, R.; Negi, R.; Kumar, S.; Singh, S.; Rustagi, S.; Shreaz, S.; Rai, A.K.; Kour, D.; Yadav, A.N. Microbial consortium with multifunctional attributes for the plant growth of eggplant (Solanum melongena L.). Folia Microbiol. 2024, 69, 1255–1266. [Google Scholar] [CrossRef]
- Timofeeva, A.; Galyamova, M.; Sedykh, S. Prospects for using phosphate-solubilizing microorganisms as natural fertilizers in agriculture. Plants 2022, 11, 2119. [Google Scholar] [CrossRef]
- Chang, W.; Yang, C.; Liu, T.; Tian, P.; Zhang, S.; Dai, X.; Igarashi, Y.; Luo, F. Revealing the phosphate-solubilizing characteristics and mechanisms of the plant growth-promoting bacterium Agrobacterium deltaense C1. J. Appl. Microbiol. 2024, 135, lxad284. [Google Scholar] [CrossRef]
- Mendoza-Arroyo, G.E.; Chan-Bacab, M.J.; Aguila-Ramírez, R.N.; Ortega-Morales, B.O.; Canché Solís, R.E.; Chab-Ruiz, A.O.; Cob-Rivera, K.I.; Dzib-Castillo, B.; Tun-Che, R.E.; Camacho-Chab, J.C. Inorganic phosphate solubilization by a novel isolated bacterial strain Enterobacter sp. ITCB-09 and its application potential as biofertilizer. Agriculture 2020, 10, 383. [Google Scholar] [CrossRef]
- Saha, K.K.; Mandal, S.; Barman, A.; Mondal, S.; Chatterjee, S.; Mandal, N.C. Genomic insight of phosphate solubilization and plant growth promotion of two taxonomically distinct winter crops by Enterobacter sp. DRP3. J. Appl. Microbiol. 2024, 135, lxae146. [Google Scholar] [CrossRef]

| Strains | Host Legume | Identified Strain/ Access Number in NCBI GenBank |
|---|---|---|
| Phosphate-solubilizing bacterial strains | ||
| Sfcm-014-01 | Centrosema macrocarpum | Micrococcus sp. Sfcm-014-01/PQ215700 |
| Sfl-043-09 | Leucaena leucocephala | Agrobacterium sp. Sfl-043-09/PP319609 |
| Sfcm-014-02 | Centrosema macrocarpum | Enterobacter sp. Sfcm-014-02/PP319605 |
| Sfcm-054-06 | Centrosema macrocarpum | Enterobacter sp. Sfcm-054-06/PP319604 |
| Rhizobial strains | ||
| Rl-012-02 | Leucaena leucocephala | Ensifer terangae Rl-012-02/PQ345348 |
| Rcm-025-01 | Centrosema macrocarpum | Bradyrhizobium glycinis Rcm-025-01/PQ356800 |
| Sample | pH | EC (µs cm−1) | OM (%) | P (ppm) | K (ppm) | Sand (%) | Silt (%) | Clay (%) | Textural Class |
|---|---|---|---|---|---|---|---|---|---|
| 1 | 7.025 | 26.35 | 3.2 | 10.25 | 61.77 | 52 | 30 | 18 | Sandy loam |
| Phosphate-Solubilizing Bacterial Strains | Inhibition Area (cm²) of Ensifer Terangae Rl-012-02, Effective with L. leucocephala | Inhibition Area (cm²) of Bradyrhizobium glycinis Rcm-025-01, Effective with C. macrocarpum |
|---|---|---|
| Micrococcus sp. Sfcm-014-01 (PQ215700) | NI | NI |
| Agrobacterium sp. Sfl-043-09 (PP319609) | NI | NI |
| Enterobacter sp. Sfcm-014-02T (PP319605) | 6.37 ± 0.02 | 5.78 ± 0.02 |
| Enterobacter sp. Sfcm-054-06 (PP319604) | 5.91 ± 0.03 | 6.36 ± 0.02 |
| Strains Under Study | Strain Type | Number of Generations | Generation Time (hours) |
|---|---|---|---|
| Micrococcus sp. Sfcm-014-01 | PSB | 15.33 | 2.48 |
| Agrobacterium sp. Sfl-043-09 | PSB | 14.24 | 2.25 |
| E. terangae Rl-012-02 | Rhizobium | 20.81 | 2.11 |
| B. glycinis Rcm-025-01 | Rhizobium | 20.17 | 4.17 |
| Chlorophyll Level in the Plant (SPAD) | |||
|---|---|---|---|
| L. leucocephala | C. macrocarpum | ||
| 0 kg P ha−1 (0% P) | 0 kg P ha−1 (0% P) | ||
| Sfcm-014-01 + Rl-012-02 | 44.05 (±1.16) cdefg | Sfcm-014-01 + Rcm-025-01 | 35.83 (±0.48) h |
| Sfl-043-09 + Rl-012-02 | 43.03 (±0.87) efg | Sfl-043-09 + Rcm-025-01 | 35.60 (±0.60) h |
| Sfcm-014-01 + Sfl-043-09 + Rl-012-02 | 44.84 (±0.78) abcdef | Sfcm-014-01 + Sfl-043-09 + Rcm-025-01 | 36.03 (±0.85) h |
| Rl-012-02 | 42.06 (±1.46) fg | Rcm-025-01 | 36.69 (±0.92) gh |
| Control | 41.75 (±1.18) g | Control | 36.01 (±1.12) h |
| 22.12 kg P ha−1 (25% P) | 18.72 kg P ha−1 (25% P) | ||
| Sfcm-014-01 + Rl-012-02 | 44.46 (±1.30) bcdefg | Sfcm-014-01 + Rcm-025-01 | 41.39 (±0.60) abcd |
| Sfl-043-09 + Rl-012-02 | 44.56 (±0.26) bcdefg | Sfl-043-09 + Rcm-025-01 | 38.23 (±0.90) efgh |
| Sfcm-014-01 + Sfl-043-09 + Rl-012-02 | 44.21 (±1.50) cdefg | Sfcm-014-01 + Sfl-043-09 + Rcm-025-01 | 37.39 (±1.21) gh |
| Rl-012-02 | 43.78(±0.62) defg | Rcm-025-01 | 38.16 (±1.48) fgh |
| Control | 41.83 (±1.19) g | Control | 39.41 (±0.73) cdefg |
| 44.24 kg P ha−1 (50% P) | 37.44 kg P ha−1 (50% P) | ||
| Sfcm-014-01 + Rl-012-02 | 46.74 (±0.19) abc | Sfcm-014-01 + Rcm-025-01 | 41.37 (±1.72) abcd |
| Sfl-043-09 + Rl-012-02 | 45.26 (±0.91) abcde | Sfl-043-09 + Rcm-025-01 | 39.75 (±0.67) bcdefg |
| Sfcm-014-01 + Sfl-043-09 + Rl-012-02 | 47.47 (±1.24) a | Sfcm-014-01 + Sfl-043-09 + Rcm-025-01 | 41.29 (±0.64) abcde |
| Rl-012-02 | 44.81 (±1.48) abcdef | Rcm-025-01 | 38.56 (±0.95) cdefgh |
| Control | 45.94 (±0.60) abcd | Control | 39.58 (±1.42) cdefg |
| 66.36 kg P ha−1 (75% P) | 56.16 kg P ha−1 (75% P) | ||
| Sfcm-014-01 + Rl-012-02 | 46.68 (±1.04) abc | Sfcm-014-01 + Rcm-025-01 | 42.76 (±1.37) ab |
| Sfl-043-09 + Rl-012-02 | 47.10 (±0.49) ab | Sfl-043-09 + Rcm-025-01 | 43.42 (±1.22) a |
| Sfcm-014-01 + Sfl-043-09 + Rl-012-02 | 47.14 (±0.26) ab | Sfcm-014-01 + Sfl-043-09 + Rcm-025-01 | 42.77 (±1.07) ab |
| Rl-012-02 | 46.20 (±1.19) abcd | Rcm-025-01 | 40.87 (±1.38) abcdef |
| Control | 46.42 (±0.40) abcd | Control | 41.14 (±0.69) abcdef |
| 119.76 kg N ha−1 + 88.48 kg P ha−1 + 99.54 kg K ha−1 (100% NPK) | 119.76 kg N ha−1 + 74.89 kg P ha−1 + 59.88 kg K ha−1 (100% NPK) | ||
| Control | 47.13 (±0.84) ab | Control | 41.77 (±1.29) abc |
| p-Value | 0.0004 ** | p-Value | 0.0001 ** |
| CV (%) | 3.81 | CV (%) | 4.71 |
| Plant Height (cm) | |||
|---|---|---|---|
| L. leucocephala | C. macrocarpum | ||
| 0 kg P ha−1 (0% P) | 0 kg P ha−1 (0% P) | ||
| Sfcm-014-01 + Rl-012-02 | 22.17 (±0.83) cdef | Sfcm-014-01 + Rcm-025-01 | 260.00 (±3.46) def |
| Sfl-043-09 + Rl-012-02 | 20.67 (±0.33) efghi | Sfl-043-09 + Rcm-025-01 | 270.00 (±2.00) cde |
| Sfcm-014-01 + Sfl-043-09 + Rl-012-02 | 21.83 (±0.44) cdef | Sfcm-014-01 + Sfl-043-09 + Rcm-025-01 | 223.00 (±7.94) g |
| Rl-012-02 | 23.83 (±0.93) bc | Rcm-025-01 | 270.33 (±16.33) cde |
| Control | 20.33 (±0.60) fghi | Control | 248.50 (±13.55) efg |
| 22.12 kg P ha−1 (25% P) | 18.72 kg P ha−1 (25% P) | ||
| Sfcm-014-01 + Rl-012-02 | 22.33 (±0.44) bcdef | Sfcm-014-01 + Rcm-025-01 | 265.67 (±4.26) def |
| Sfl-043-09 + Rl-012-02 | 21.67 (±0.67) cdefg | Sfl-043-09 + Rcm-025-01 | 267.67 (±5.17) cde |
| Sfcm-014-01 + Sfl-043-09 + Rl-012-02 | 18.50 (±0.29) hi | Sfcm-014-01 + Sfl-043-09 + Rcm-025-01 | 264.33 (±13.09) def |
| Rl-012-02 | 21.33 (±0.73) cdefg | Rcm-025-01 | 248.33 (±7.26) efg |
| Control | 21.00 (±1.53) defgh | Control | 174.33 (±12.44) h |
| 44.24 kg P ha−1 (50% P) | 37.44 kg P ha−1 (50% P) | ||
| Sfcm-014-01 + Rl-012-02 | 22.5 0(±1.32) bcdef | Sfcm-014-01 + Rcm-025-01 | 280.00 (±2.31) bcd |
| Sfl-043-09 + Rl-012-02 | 21.50 (±0.58) cdefg | Sfl-043-09 + Rcm-025-01 | 318.00 (±9.17) a |
| Sfcm-014-01 + Sfl-043-09 + Rl-012-02 | 20.50 (±0.50) efghi | Sfcm-014-01 + Sfl-043-09 + Rcm-025-01 | 296.67 (±6.01) abc |
| Rl-012-02 | 18.33 (±0.33) i | Rcm-025-01 | 316.67 (±8.82) a |
| Control | 19.17 (±1.64) ghi | Control | 288.67 (±15.93) abcd |
| 66.36 kg P ha−1 (75% P) | 56.16 kg P ha−1 (75% P) | ||
| Sfcm-014-01 + Rl-012-02 | 23.33 (±1.09) bcd | Sfcm-014-01 + Rcm-025-01 | 227.00 (±14.57) g |
| Sfl-043-09 + Rl-012-02 | 27.17 (±1.20) a | Sfl-043-09 + Rcm-025-01 | 236.67 (±8.74) fg |
| Sfcm-014-01 + Sfl-043-09 + Rl-012-02 | 27.00 (±1.00) a | Sfcm-014-01 + Sfl-043-09 + Rcm-025-01 | 274.67 (±7.42) cde |
| Rl-012-02 | 20.67 (±1.20) efghi | Rcm-025-01 | 271.67 (±1.67) cde |
| Control | 24.83 (±0.60) ab | Control | 263.33 (±17.17) def |
| 119.76 kg N ha−1 + 88.48 kg P ha−1 + 99.54 kg K ha−1 (100% NPK) | 119.76 kg N ha−1 + 74.89 kg P ha−1 + 59.88 kg K ha−1 (100% NPK) | ||
| Control | 22.92 (±0.58) bcde | Control | 304.67 (±13.48) ab |
| p-Value | 0.0001 ** | p-Value | 0.0001 ** |
| CV (%) | 7.03 | CV (%) | 6.73 |
| Dry Biomass of Aerial Part (mg plant−1) | |||
|---|---|---|---|
| L. leucocephala | C. macrocarpum | ||
| 0 kg P ha−1 (0% P) | 0 kg P ha−1 (0% P) | ||
| Sfcm-014-01 + Rl-012-02 | 372.16 (±19.92) ij | Sfcm-014-01 + Rcm-025-01 | 1092.45 (±184.89) ghij |
| Sfl-043-09 + Rl-012-02 | 492.38 (±64.45) efgh | Sfl-043-09 + Rcm-025-01 | 1209.88 (±68.74) fghi |
| Sfcm-014-01 + Sfl-043-09 + Rl-012-02 | 207.19 (±18.93) k | Sfcm-014-01 + Sfl-043-09 + Rcm-025-01 | 851.70 (±70.73) j |
| Rl-012-02 | 293.38 (±16.20) jk | Rcm-025-01 | 896.79 (±139.76) ij |
| Control | 376.02 (±11.33) hij | Control | 946.46 (±151.55) ij |
| 22.12 kg P ha−1 (25% P) | 18.72 kg P ha−1 (25% P) | ||
| Sfcm-014-01 + Rl-012-02 | 389.44 (±12.12) ghij | Sfcm-014-01 + Rcm-025-01 | 1525.45 (±39.29) bcde |
| Sfl-043-09 + Rl-012-02 | 522.40 (±26.21) def | Sfl-043-09 + Rcm-025-01 | 1329.71 (±87.84) efg |
| Sfcm-014-01 + Sfl-043-09 + Rl-012-02 | 460.86 (±76.14) efghi | Sfcm-014-01 + Sfl-043-09 + Rcm-025-01 | 1502.88 (±71.39) cdef |
| Rl-012-02 | 430.51 (±61.54) fghi | Rcm-025-01 | 972.59 (±84.96) hij |
| Control | 418.33 (±18.59) fghi | Control | 1055.45 (±56.02) ghij |
| 44.24 kg P ha−1 (50% P) | 37.44 kg P ha−1 (50% P) | ||
| Sfcm-014-01 + Rl-012-02 | 435.32 (±31.56) fghi | Sfcm-014-01 + Rcm-025-01 | 1327.98 (±45.48) efg |
| Sfl-043-09 + Rl-012-02 | 611.69 (±22.01) bcd | Sfl-043-09 + Rcm-025-01 | 1672.83 (±84.89) abcd |
| Sfcm-014-01 + Sfl-043-09 + Rl-012-02 | 558.40 (±17.37) cde | Sfcm-014-01 + Sfl-043-09 + Rcm-025-01 | 1473.83 (±67.71) def |
| Rl-012-02 | 494.81 (±16.56) defg | Rcm-025-01 | 1761.75 (±124.63) abcd |
| Control | 731.55 (±27.20) a | Control | 1522.03 (±52.39) bcdef |
| 66.36 kg P ha−1 (75% P) | 56.16 kg P ha−1 (75% P) | ||
| Sfcm-014-01 + Rl-012-02 | 437.75 (±15.30) fghi | Sfcm-014-01 + Rcm-025-01 | 1282.41 (±207.92) efgh |
| Sfl-043-09 + Rl-012-02 | 671.34 (±67.06) abc | Sfl-043-09 + Rcm-025-01 | 1808.75 (±173.37) abc |
| Sfcm-014-01 + Sfl-043-09 + Rl-012-02 | 771.69 (±10.91) a | Sfcm-014-01 + Sfl-043-09 + Rcm-025-01 | 1772.29 (±180.29) abcd |
| Rl-012-02 | 706.08 (±51.71) ab | Rcm-025-01 | 1835.09 (±55.96) ab |
| Control | 660.63 (±89.26) abc | Control | 1704.01 (±45.01) abcd |
| 119.76 kg N ha−1 + 88.48 kg P ha−1 + 99.54 kg K ha−1 (100% NPK) | 119.76 kg N ha−1 + 74.89 kg P ha−1 + 59.88 kg K ha−1 (100% NPK) | ||
| Control | 682.66 (±38.40) ab | Control | 1981.70 (±16.16) a |
| p-Value | 0.0001 ** | p-Value | 0.0001 ** |
| CV (%) | 14.01 | CV (%) | 13.56 |
| Dry Root Biomass (mg plant−1) | |||
|---|---|---|---|
| L. leucocephala | C. macrocarpum | ||
| 0 kg P ha−1 (0% P) | 0 kg P ha−1 (0% P) | ||
| Sfcm-014-01 + Rl-012-02 | 348.28 (±16.09) defg | Sfcm-014-01 + Rcm-025-01 | 225.93 (±79.13) efg |
| Sfl-043-09 + Rl-012-02 | 417.06 (±47.43) cde | Sfl-043-09 + Rcm-025-01 | 277.58 (±37.22) cdef |
| Sfcm-014-01 + Sfl-043-09 + Rl-012-02 | 346.29 (±75.85) defg | Sfcm-014-01 + Sfl-043-09 + Rcm-025-01 | 161.53 (±8.15) g |
| Rl-012-02 | 336.71 (±28.71) efg | Rcm-025-01 | 197.33 (±33.87) fg |
| Control | 331.45 (±21.21) efg | Control | 235.31 (±11.24) efg |
| 22.12 kg P ha−1 (25% P) | 18.72 kg P ha−1 (25% P) | ||
| Sfcm-014-01 + Rl-012-02 | 279.20 (±4.72) g | Sfcm-014-01 + Rcm-025-01 | 273.60 (±11.17) def |
| Sfl-043-09 + Rl-012-02 | 411.63 (±10.97) cde | Sfl-043-09 + Rcm-025-01 | 315.27 (±41.01) bcde |
| Sfcm-014-01 + Sfl-043-09 + Rl-012-02 | 411.93 (±34.63) cde | Sfcm-014-01 + Sfl-043-09 + Rcm-025-01 | 374.40 (±21.18) abc |
| Rl-012-02 | 384.63 (±13.55) cdef | Rcm-025-01 | 216.07(±27.74) efg |
| Control | 392.78 (±12.14) cdef | Control | 220.28 (±10.26) efg |
| 44.24 kg P ha−1 (50% P) | 37.44 kg P ha−1 (50% P) | ||
| Sfcm-014-01 + Rl-012-02 | 573.81 (±55.25) a | Sfcm-014-01 + Rcm-025-01 | 290.03 (±26.91) bcdef |
| Sfl-043-09 + Rl-012-02 | 560.57 (±17.03) ab | Sfl-043-09 + Rcm-025-01 | 384.20 (±22.38) ab |
| Sfcm-014-01 + Sfl-043-09 + Rl-012-02 | 408.55 (±32.16) cde | Sfcm-014-01 + Sfl-043-09 + Rcm-025-01 | 302.59 (±8.02) bcde |
| Rl-012-02 | 303.25 (±17.83) fg | Rcm-025-01 | 351.21 (±23.11) abcd |
| Control | 377.53 (±11.62) cdef | Control | 295.56 (±17.63) bcdef |
| 66.36 kg P ha−1 (75% P) | 56.16 kg P ha−1 (75% P) | ||
| Sfcm-014-01 + Rl-012-02 | 423.18 (±61.43) cde | Sfcm-014-01 + Rcm-025-01 | 387.55 (±32.68) ab |
| Sfl-043-09 + Rl-012-02 | 578.27 (±39.52) a | Sfl-043-09 + Rcm-025-01 | 421.74 (±44.43) a |
| Sfcm-014-01 + Sfl-043-09 + Rl-012-02 | 467.23 (±20.07) bc | Sfcm-014-01 + Sfl-043-09 + Rcm-025-01 | 416.86 (±82.32) a |
| Rl-012-02 | 552.23 (±35.52) ab | Rcm-025-01 | 364.17 (±28.40) abcd |
| Control | 434.28 (±8.62) cd | Control | 378.58 (±7.69) ab |
| 119.76 kg N ha−1 + 88.48 kg P ha−1 + 99.54 kg K ha−1 (100% NPK) | 119.76 kg N ha−1 + 74.89 kg P ha−1 + 59.88 kg K ha−1 (100% NPK) | ||
| Control | 577.53 (±36.62) a | Control | 430.09 (±20.56) a |
| p-Value | 0.0001 ** | p-Value | 0.0001 ** |
| CV (%) | 13.92 | CV (%) | 19.38 |
| Root Length (cm) | |||
|---|---|---|---|
| L. leucocephala | C. macrocarpum | ||
| 0 kg P ha−1 (0% P) | 0 kg P ha−1 (0% P) | ||
| Sfcm-014-01 + Rl-012-02 | 21.00 (±0.58) efg | Sfcm-014-01 + Rcm-025-01 | 24.67 (±0.67) efgh |
| Sfl-043-09 + Rl-012-02 | 21.67 (±0.33) def | Sfl-043-09 + Rcm-025-01 | 25.67 (±0.88) defgh |
| Sfcm-014-01 + Sfl-043-09 + Rl-012-02 | 18.00 (±0.00) hi | Sfcm-014-01 + Sfl-043-09 + Rcm-025-01 | 23.33 (±0.33) h |
| Rl-012-02 | 18.67(±0.33) hi | Rcm-025-01 | 24.33 (±0.33) fgh |
| Control | 17.00(±0.58) i | Control | 23.33 (±0.33) h |
| 22.12 kg P ha−1 (25% P) | 18.72 kg P ha−1 (25% P) | ||
| Sfcm-014-01 + Rl-012-02 | 22.67 (±0.33) cde | Sfcm-014-01 + Rcm-025-01 | 25.00 (±0.00) efgh |
| Sfl-043-09 + Rl-012-02 | 23.00 (±0.00) bcd | Sfl-043-09 + Rcm-025-01 | 26.67 (±0.33) bcde |
| Sfcm-014-01 + Sfl-043-09 + Rl-012-02 | 24.33 (±0.33) abc | Sfcm-014-01 + Sfl-043-09 + Rcm-025-01 | 23.00 (±0.00) h |
| Rl-012-02 | 21.67 (±1.33) def | Rcm-025-01 | 23.33 (±0.83) h |
| Control | 17.50 (±0.76) i | Control | 23.33 (±1.69) h |
| 44.24 kg P ha−1 (50% P) | 37.44 kg P ha−1 (50% P) | ||
| Sfcm-014-01 + Rl-012-02 | 21.00 (±1.00) efg | Sfcm-014-01 + Rcm-025-01 | 23.67 (±0.33) gh |
| Sfl-043-09 + Rl-012-02 | 24.33 (±0.33) abc | Sfl-043-09 + Rcm-025-01 | 28.67 (±0.67) ab |
| Sfcm-014-01 + Sfl-043-09 + Rl-012-02 | 19.67 (±0.67) gh | Sfcm-014-01 + Sfl-043-09 + Rcm-025-01 | 26.00 (±0.58) cdef |
| Rl-012-02 | 23.00 (±0.58) bcd | Rcm-025-01 | 24.33 (±0.33) fgh |
| Control | 24.00(±0.58) abc | Control | 26.17 (±0.73) cdef |
| 66.36 kg P ha−1 (75% P) | 56.16 kg P ha−1 (75% P) | ||
| Sfcm-014-01 + Rl-012-02 | 24.33 (±0.67) abc | Sfcm-014-01 + Rcm-025-01 | 24.33 (±0.33) fgh |
| Sfl-043-09 + Rl-012-02 | 25.00 (±0.00) a | Sfl-043-09 + Rcm-025-01 | 29.67 (±0.88) a |
| Sfcm-014-01 + Sfl-043-09 + Rl-012-02 | 23.33 (±0.67) abcd | Sfcm-014-01 + Sfl-043-09 + Rcm-025-01 | 27.33 (±1.45) bcd |
| Rl-012-02 | 24.67 (±0.33) ab | Rcm-025-01 | 24.67 (±0.88) efgh |
| Control | 21.17 (±0.73) efg | Control | 27.17 (±0.73) bcd |
| 119.76 kg N ha−1 + 88.48 kg P ha−1 + 99.54 kg K ha−1 (100% NPK) | 119.76 kg N ha−1 + 74.89 kg P ha−1 + 59.88 kg K ha−1 (100% NPK) | ||
| Control | 20.67 (±0.73) fg | Control | 28.00 (±0.58) abc |
| p-Value | 0.0001 ** | p-Value | 0.0001 ** |
| CV (%) | 4.84 | CV (%) | 5.03 |
| Leaf Phosphorus (ppm) | |||
|---|---|---|---|
| L. leucocephala | C. macrocarpum | ||
| 0 kg P ha−1 (0% P) | 0 kg P ha−1 (0% P) | ||
| Sfcm-014-01 + Rl-012-02 | 173.23 (±4.16) abcdefgh | Sfcm-014-01 + Rcm-025-01 | 240.00 (±40.70) hij |
| Sfl-043-09 + Rl-012-02 | 148.07 (±4.42) efghi | Sfl-043-09 + Rcm-025-01 | 245.33 (±22.02) hij |
| Sfcm-014-01 + Sfl-043-09 + Rl-012-02 | 164.07 (±7.51) cdefgh | Sfcm-014-01 + Sfl-043-09 + Rcm-025-01 | 243.33 (±2.96) hij |
| Rl-012-02 | 143.40 (±7.23) abcde | Rcm-025-01 | 254.33 (±13.74) bcde |
| Control | 121.70(±0.56) i | Control | 213.00 (±17.01) j |
| 22.12 kg P ha−1 (25% P) | 18.72 kg P ha−1 (25% P) | ||
| Sfcm-014-01 + Rl-012-02 | 178.73 (±1.89) abcde | Sfcm-014-01 + Rcm-025-01 | 260.67 (±13.20) fghij |
| Sfl-043-09 + Rl-012-02 | 150.00 (±17.73) defghi | Sfl-043-09 + Rcm-025-01 | 291.00 (±2.65) cdefgh |
| Sfcm-014-01 + Sfl-043-09 + Rl-012-02 | 184.36 (±8.47) abc | Sfcm-014-01 + Sfl-043-09 + Rcm-025-01 | 303.00 (±18.77) bcdefg |
| Rl-012-02 | 176.20 (±18.02) abcdef | Rcm-025-01 | 270.33 (±6.69) ghij |
| Control | 142.27 (±20.52) hi | Control | 226.67 (±9.39) ij |
| 44.24 kg P ha−1 (50% P) | 37.44 kg P ha−1 (50% P) | ||
| Sfcm-014-01 + Rl-012-02 | 174.40 (±10.27) abcdefgh | Sfcm-014-01 + Rcm-025-01 | 325.33 (±11.61) abcd |
| Sfl-043-09 + Rl-012-02 | 181.00 (±1.73) abcd | Sfl-043-09 + Rcm-025-01 | 317.67 (±14.66) abcde |
| Sfcm-014-01 + Sfl-043-09 + Rl-012-02 | 197.37 (±8.61) ab | Sfcm-014-01 + Sfl-043-09 + Rcm-025-01 | 312.00 (±6.56) abcdef |
| Rl-012-02 | 173.80 (±10.41) abcdefgh | Rcm-025-01 | 272.00 (±17.06) defghi |
| Control | 146.00 (±30.19) fghi | Control | 253.00 (±4.04) ghij |
| 66.36 kg P ha−1 (75% P) | 56.16 kg P ha−1 (75% P) | ||
| Sfcm-014-01 + Rl-012-02 | 174.57 (±2.38) abcdefg | Sfcm-014-01 + Rcm-025-01 | 330.00 (±15.28) abc |
| Sfl-043-09 + Rl-012-02 | 177.50 (±11.19) abcdef | Sfl-043-09 + Rcm-025-01 | 334.33 (±28.20) abc |
| Sfcm-014-01 + Sfl-043-09 + Rl-012-02 | 186.67 (±10.48) abc | Sfcm-014-01 + Sfl-043-09 + Rcm-025-01 | 353.67 (±13.68) ab |
| Rl-012-02 | 178.67 (±7.26) abcde | Rcm-025-01 | 317.67 (±26.74) abcde |
| Control | 168.33 (±11.26) bcdefgh | Control | 309.33 (±25.57) bcdef |
| 119.76 kg N ha−1 + 88.48 kg P ha−1 + 99.54 kg K ha−1 (100% NPK) | 119.76 kg N ha−1 + 74.89 kg P ha−1 + 59.88 kg K ha−1 (100% NPK) | ||
| Control | 201.67 (±12.33) a | Control | 365.33 (±32.84) a |
| p-Value | 0.0001 ** | p-Value | 0.0001 ** |
| CV (%) | 12.32 | CV (%) | 11.50 |
| Soil Phosphorus (ppm) | |||
|---|---|---|---|
| L. leucocephala | C. macrocarpum | ||
| 0 kg P ha−1 (0% P) | 0 kg P ha−1 (0% P) | ||
| Sfcm-014-01 + Rl-012-02 | 5.49 (±0.02) h | Sfcm-014-01 + Rcm-025-01 | 3.74 (±0.01) l |
| Sfl-043-09 + Rl-012-02 | 5.82 (±0.07) h | Sfl-043-09 + Rcm-025-01 | 4.41 (±0.04) h |
| Sfcm-014-01 + Sfl-043-09 + Rl-012-02 | 5.58 (±0.01) h | Sfcm-014-01 + Sfl-043-09 + Rcm-025-01 | 5.41 (±0.01) fg |
| Rl-012-02 | 6.09 (±0.03) g | Rcm-025-01 | 4.58 (±0.00) gh |
| Control | 5.07 (±0.00) h | Control | 2.26 (±0.06) j |
| 22.12 kg P ha−1 (25% P) | 18.72 kg P ha−1 (25% P) | ||
| Sfcm-014-01 + Rl-012-02 | 6.82 (±0.05) g | Sfcm-014-01 + Rcm-025-01 | 5.57 (±0.04) f |
| Sfl-043-09 + Rl-012-02 | 7.27 (±0.02) g | Sfl-043-09 + Rcm-025-01 | 5.41 (±0.09) efg |
| Sfcm-014-01 + Sfl-043-09 + Rl-012-02 | 7.57 (±0.09) fg | Sfcm-014-01 + Sfl-043-09 + Rcm-025-01 | 5.74 (±0.00) f |
| Rl-012-02 | 6.91 (±0.07) g | Rcm-025-01 | 4.91 (±0.02) g |
| Control | 6.90 (±0.03) g | Control | 3.74 (±0.00) l |
| 44.24 kg P ha−1 (50% P) | 37.44 kg P ha−1 (50% P) | ||
| Sfcm-014-01 + Rl-012-02 | 7.82 (±0.14) defg | Sfcm-014-01 + Rcm-025-01 | 6.91 (±0.08) abcd |
| Sfl-043-09 + Rl-012-02 | 8.74 (±0.06) cde | Sfl-043-09 + Rcm-025-01 | 6.57 (±0.01) d |
| Sfcm-014-01 + Sfl-043-09 + Rl-012-02 | 9.15 (±0.13) bc | Sfcm-014-01 + Sfl-043-09 + Rcm-025-01 | 5.80 (±0.04) ef |
| Rl-012-02 | 7.15 (±0.01) g | Rcm-025-01 | 5.07 (±0.00) g |
| Control | 8.55 (±0.06) cde | Control | 6.24 (±0.00) de |
| 66.36 kg P ha−1 (75% P) | 56.16 kg P ha−1 (75% P) | ||
| Sfcm-014-01 + Rl-012-02 | 8.40 (±0.04) cef | Sfcm-014-01 + Rcm-025-01 | 7.24 (±0.02) b |
| Sfl-043-09 + Rl-012-02 | 10.23 (±0.11) b | Sfl-043-09 + Rcm-025-01 | 7.49 (±0.03) ab |
| Sfcm-014-01 + Sfl-043-09 + Rl-012-02 | 13.73 (±0.02) a | Sfcm-014-01 + Sfl-043-09 + Rcm-025-01 | 7.69 (±0.03) a |
| Rl-012-02 | 8.24 (±0.03) cef | Rcm-025-01 | 6.24 (±0.00) de |
| Control | 8.69 (±0.02) ce | Control | 6.38 (±0.03) d |
| 119.76 kg N ha−1 + 88.48 kg P ha−1 + 99.54 kg K ha−1 (100% NPK) | 119.76 kg N ha−1 + 74.89 kg P ha−1 + 59.88 kg K ha−1 (100% NPK) | ||
| Control | 9.15(±0.00) bcd | Control | 6.94 (±0.03) c |
| p-Value | 0.0001 ** | p-Value | 0.0001 ** |
| CV (%) | 1.38 | CV (%) | 1.12 |
Disclaimer/Publisher’s Note: The statements, opinions and data contained in all publications are solely those of the individual author(s) and contributor(s) and not of MDPI and/or the editor(s). MDPI and/or the editor(s) disclaim responsibility for any injury to people or property resulting from any ideas, methods, instructions or products referred to in the content. |
© 2024 by the authors. Licensee MDPI, Basel, Switzerland. This article is an open access article distributed under the terms and conditions of the Creative Commons Attribution (CC BY) license (https://creativecommons.org/licenses/by/4.0/).
Share and Cite
Ríos-Ruiz, W.F.; Castro-Tuanama, R.; Valdez-Nuñez, R.A.; Torres-Bernal, L.; Jave-Concepción, H.G.; Daza-Pérez, A.C.; Barrera-Lozano, M.; Archentti-Reátegui, F. Co-Inoculation of Phosphate-Solubilizing Bacteria and Rhizobia Increases Phosphorus Availability and Promotes the Development of Forage Legumes. Agronomy 2024, 14, 2493. https://doi.org/10.3390/agronomy14112493
Ríos-Ruiz WF, Castro-Tuanama R, Valdez-Nuñez RA, Torres-Bernal L, Jave-Concepción HG, Daza-Pérez AC, Barrera-Lozano M, Archentti-Reátegui F. Co-Inoculation of Phosphate-Solubilizing Bacteria and Rhizobia Increases Phosphorus Availability and Promotes the Development of Forage Legumes. Agronomy. 2024; 14(11):2493. https://doi.org/10.3390/agronomy14112493
Chicago/Turabian StyleRíos-Ruiz, Winston Franz, Rony Castro-Tuanama, Renzo Alfredo Valdez-Nuñez, Lenin Torres-Bernal, Henry Giovani Jave-Concepción, Aurora Consuelo Daza-Pérez, Marvin Barrera-Lozano, and Fernando Archentti-Reátegui. 2024. "Co-Inoculation of Phosphate-Solubilizing Bacteria and Rhizobia Increases Phosphorus Availability and Promotes the Development of Forage Legumes" Agronomy 14, no. 11: 2493. https://doi.org/10.3390/agronomy14112493
APA StyleRíos-Ruiz, W. F., Castro-Tuanama, R., Valdez-Nuñez, R. A., Torres-Bernal, L., Jave-Concepción, H. G., Daza-Pérez, A. C., Barrera-Lozano, M., & Archentti-Reátegui, F. (2024). Co-Inoculation of Phosphate-Solubilizing Bacteria and Rhizobia Increases Phosphorus Availability and Promotes the Development of Forage Legumes. Agronomy, 14(11), 2493. https://doi.org/10.3390/agronomy14112493

